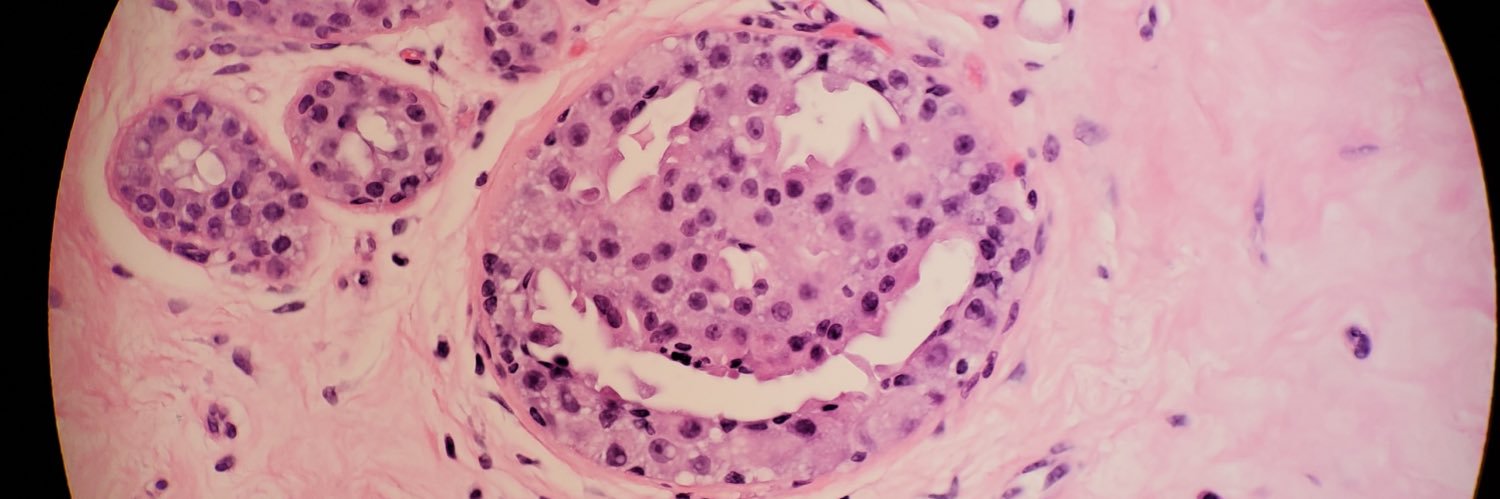
David Afework, MD banner

Sabitlenmiş Tweet

I’m excited to announce that I’ll be taking my talents to @ohsupathology !! 💪🏾😁🔬
this is your sign to never give up on your dreams 🙏🏾
#pathology #rusmmatchday #match2023 #path2path

David Afework, MD@DavidAfeworkMD
the euphoria is going crazy right now 🔥 I’m going to become a Pathologist 😭 #pathtwitter #MedTwitter #matchday2023 #rusmmatchday
English